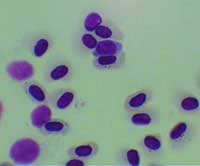

8 loài vi sinh vật xâm hại nguy hiểm nhất thế giới
![]() |
Aphanomyces Astaci |
Aphanomyces astaci là một loại nấm sống trong nước ngọt và ký sinh ở tôm. Loại bệnh này đã và đã làm giảm sút trầm trọng trữ lượng tôm và có nguy cơ làm tuyệt chủng một vài loài trong tổng số 5 loài tôm bản địa của Châu Âu.
2. Bệnh thối hoa chuối: Banana bunchy top virus
Virut bệnh thối hoa chuối là một mầm bệnh gây ra bệnh đỉnh hoa ở chuối. Véc tơ truyền bệnh là rệp cây Pentalonia nigronervosa và được coi là bệnh gây tổn thất kinh tế nghiêm trọng nhất trong số các bệnh ở chuối trên toàn thế giới.
![]() |
Batrachochytrium Dendroba |
Nấm bào tử ếch nhái được phát hiện lần đầu tiên vào năm 1998 bởi một nhóm các nhà khoa học quốc tế của Úc, Mỹ và Anh và kể từ đó nấm này được coi là nguyên nhân làm suy giảm nghiêm trọng về số lượng của các loài ếch nhái ở những vùng nguyên sơ thuộc Panama và Úc.
4. Bệnh thối cây dẻ: Cryphonectria parasitica
Bệnh thối cây dẻ do loài nấm gây thối cành và thân cây hạt dẻ. Sau khi nhiễm qua các vết thương trên vỏ cây, nấm xâm nhập sâu vào thân cây, gây chết cây ở phần trên của vết lây nhiễm. Loài nấm này đã tiêu diệt hầu hết cây hạt dẻ của châu Mỹ.
5. Bệnh sốt rét chim: Plasmodium relictum
Trùng bào tử ký sinh được muỗi truyền và gây bệnh sốt rét ở chim (bệnh sốt rét chim) có thể gây chết cho các loài dễ nhiễm bệnh (chim cánh cụt) và chim (ở đảo Hawaii), là những nơi chưa có mặt loài ký sinh trùng của bệnh sốt rét này.
![]() |
Ophiostoma Ulmi |
Bệnh héo rũ cây Du và có thể gây chết cây do loài nấm Ophiostoma ulmi. Loài nấm này được truyền do bọ cánh cứng ăn vỏ cây và qua cành ghép. Loài nấm này gây bệnh trầm trọng cho cây Du ở vùng Nam Mỹ và Châu Âu.
7. Bệnh dịch virus Rinde: Rinderpest virus
Bệnh dịch virus Rinde ở các loài móng guốc chẵn. Bệnh gây viêm loét các màng nhầy đường tiêu hoá và làm cho con vật bị chết rất nhanh. Bệnh còn lưu hành ở nhiều vùng thuộc Châu Phi, Trung Đông và Nam Á.
![]() |
Phytophthora Cinnamomi |
P. cinnamomi là một loại nấm rễ gây bệnh tắc mạch dẫn và gây chết đối với nhiều loài thực vật. Bệnh phát triển mạnh trong môi trường ẩm và ký sinh trên rễ và mô thân gần gốc. Bệnh làm suy yếu hoặc giết chết cây vì gây cản trở việc vận chuyển nước và dinh dưỡng trong cây.
![]() | ![]() | ||
Plasmodium Relictum |
| Rinderpest Virus |
![]() | ![]() | ||
Cryphonectria Parasitica | Pentalonia Nigronervosa |
(Những loài trong danh sách này được chọn để minh hoạ cho các tác hại của sinh vật xâm hại. Những loài không có trong danh sách không có nghĩa là kém nguy hiểm hơn)
Những loài hoa tiêu biểu của mùa xuân
Hoa đào miền bắc, hoa mai miền nam là hai loài đặc trưng và được cho là biểu tượng của mùa xuân Việt Nam.
Hàng loạt cây cảnh chứa chất độc chết người
Các nhà sinh học cảnh báo trong số cây cảnh trồng trong nhà có nhiều loại cây chứa độc tố gây chết người nếu ăn phải.
Phân biệt đào bích và đào phai
Đào phai và đào bích là hai loại hoa đào Tết khá phổ biến và được nhiều người yêu thích.
13 loài hoa hiếm và đẹp nhất thế giới
Vượt qua 270.000 "ứng cử viên", 13 loài hoa dưới đây không chỉ khiến bạn ngất ngây bởi vẻ đẹp của nó mà còn ngạc nhiên bởi đây đều là những loài hoa vô cùng hiếm gặp.
Top 10 loại nấm quý hiếm nhất ở Việt Nam
Hiện nay các loại nấm là món ăn ưa thích của nhiều người. Không chỉ có giá trị dinh dưỡng cao chúng còn là nguyên liệu để chế biến những món ăn hấp dẫn.
8 loại ký sinh trùng có nguy cơ lẩn trốn trong thức ăn bạn ăn hàng ngày
Nếu không cẩn thận, bạn hoàn toàn có thể ăn phải những ký sinh trùng này mà không hề hay biết.